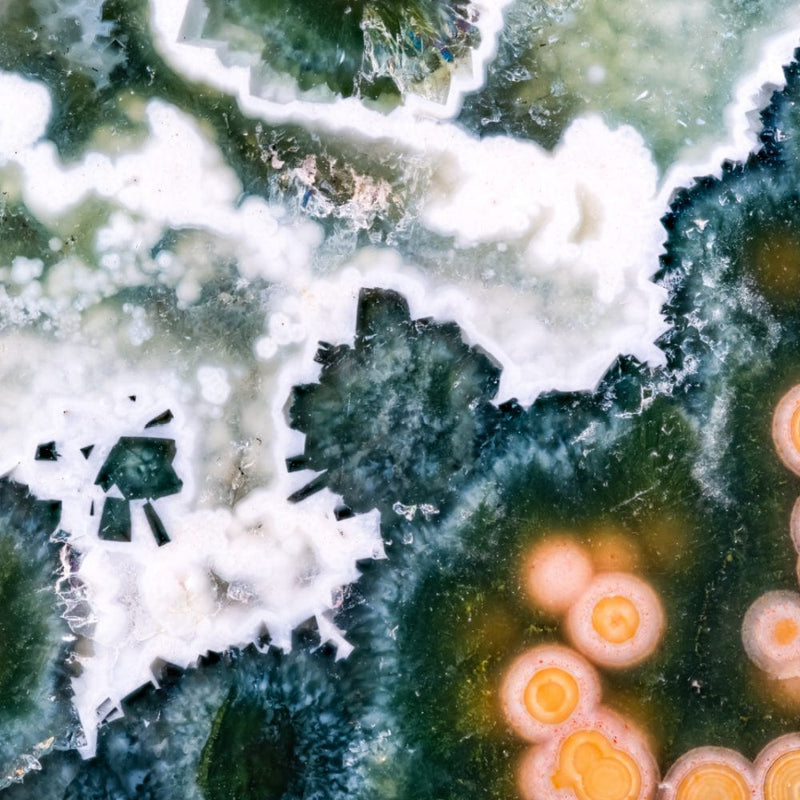

Ocean Jasper is, without a doubt, my all-time favorite crystal. Years ago, when I worked in fine jewelry, I stumbled upon it at a gem and mineral convention—or rather, it found me. From across the room, it called to me, its energy impossible to ignore. The moment I picked it up, I was completely captivated, and what began as a chance encounter quickly turned into a lifelong love affair.
Every crystal dealer has their personal favorite, and for me, Ocean Jasper is pure magic. Its beauty is undeniable, but it’s the way it makes me feel that truly sets it apart. My home shelves are lined with a highly prized collection of Vein 8 Ocean Jasper, a rare variety known for its distinctive spotting and hypnotic patterns. This particular vein has long since run dry, making it an even more treasured find among collectors. Those who share my obsession understand its magnetic glow, the way it seems to pulse with energy, offering both comfort and quiet strength.
I do my best to source Ocean Jasper that mirrors this breathtaking patterning, not just because it’s visually stunning, but because it carries an incredibly soothing presence. The past few years have been filled with uncertainty, change, and emotional waves. Ocean Jasper reminds us to ride the tides of life with grace, helping us find balance amidst the chaos.
I truly believe that if everyone had just a small piece of this incredible stone, the world would feel a little warmer, softer, and more compassionate. It has the power to ground us, uplift us, and reconnect us to love and understanding. My hope is that this blog shines a light on the magic of Ocean Jasper—and maybe, just maybe, you’ll fall in love with it too.
Table of Content
Where is Ocean Jasper Found?
Ocean Jasper is found exclusively in Madagascar , off the coast of Africa. This rare and stunning stone originates from the remote shores of the country’s northwestern coastline, near the village of Marovato in the Ambolobozo Peninsula. The deposits were uniquely located at the edge of the ocean , only accessible at low tide , which is how it got its name.
Discovery and History
Although Ocean Jasper was officially rediscovered in 1999 by Paul Obeniche, a gem dealer who spent years searching for its source, its history goes back much further. There were early mentions of similar patterned jasper specimens in the 1920s , but their location remained a mystery. Obeniche and his team combed through Madagascar’s coastline, and after an extensive search, they finally found this breathtaking stone in a completely remote and nearly inaccessible location.
Mining the stone was no easy task. Because the deposits were along the water’s edge, miners could only extract it when the tide was out. This made Ocean Jasper a limited and highly prized crystal. Over time, multiple veins were discovered, each with its own distinct characteristics and colors, including greens, yellows, pinks, reds, and intricate orb-like formations.
Is Ocean Jasper Still Mined Today?
The original Ocean Jasper deposits are now depleted , and the mine at Marovato is no longer actively producing. Some later veins, like Vein 8 , became especially popular for their striking orbs and patterns, but even those have run dry. Today, Ocean Jasper can only be found through private collectors, crystal dealers, and secondary markets. Occasionally, new varieties of orbicular jasper from Madagascar are discovered, but true Ocean Jasper from the original mines remains increasingly rare.
This exclusivity makes it even more special—not just for its beauty but for the energy of the land and ocean it carries within it . If you come across a piece that speaks to you, know that it holds a unique history, formed millions of years ago and brought to light by the rhythm of the tides.
The Mohs Scale of Hardness is a ranking system used to measure a mineral's resistance to scratching. It ranges from 1 (talc, the softest) to 10 (diamond, the hardest) . Each mineral can scratch those below it and be scratched by those above it.
Ocean Jasper on the Mohs Scale:
- It is relatively hard and resistant to scratching from materials ranked lower than 6.5 (such as fluorite or calcite).
- It can be scratched by harder materials like topaz (8) or corundum (9, which includes sapphires and rubies).
Why Should You Care?
- Durability – Ocean Jasper is durable enough for daily use in jewelry, grids, or handling without scratching easily.
- Care & Cleaning – Since it ranks at 6.5, you should avoid using abrasive cleaners or rubbing it against harder minerals.
- Storage & Handling – To prevent damage, store it separately from softer stones to avoid scratches and from harder ones that might scratch it.
Ocean Jasper - Correpondences
For our tarot lovers, we love drawing connections between crystals and tarot cards—and if Ocean Jasper were a card, it would be the Queen of Cups. This queen is on a journey of self-awareness and emotional awakening, much like the energy Ocean Jasper brings. Our souls came to Earth to evolve, and while we may not always operate from our highest self, this crystal helps us find clarity, compassion, and balance in every emotional challenge. Tapping into its energy allows us to see both sides of a situation, remain centered, and transform even the most painful experiences into opportunities for love and healing. Warm, kind-hearted, and deeply intuitive, the Queen of Cups embodies the wisdom and psychic insight that Ocean Jasper carries, making it the perfect companion for those seeking emotional depth, resilience, and heart-centered growth.
Ocean Jasper is a heart healer like no other, dissolving emotional tension and replacing it with a deep sense of joy, love, and renewal. The soothing energy of this stone works in waves, gently clearing away heartbreak, self-doubt, and emotional exhaustion, making space for true healing. Stagnant emotions and energetic blockages can leave the Heart Chakra feeling heavy or closed off, but Ocean Jasper shifts that energy, encouraging balance, self-love, and deeper, more fulfilling connections. Emotional wounds from the past don’t have to define the present—this crystal acts as a gentle guide, helping you embrace love freely and trust in life’s natural flow. If stress, heartbreak, or emotional burnout have been weighing you down, **Ocean Jasper offers the reset your heart has been craving.
Solar Plexus Chakra – Love and Compassion
💚Encourages Emotional Release & Healing – Ocean Jasper dissolves stress, past wounds, and emotional blockages, allowing love and joy to flow freely.
💚Promotes Self-Love & Compassion – This crystal nurtures a deeper connection to yourself and others, fostering kindness, patience, and understanding.
💚Restores Inner Harmony & Joy – With its uplifting energy, Ocean Jasper balances emotions, reducing anxiety and bringing a sense of peace, optimism, and gratitude.
✨ Use: Place ocean jasper over your heart during meditation or wear it daily as a necklace or bracelet.
Further Readings
"I am open to love, joy, and healing, flowing with the rhythms of life as Ocean Jasper fills my heart with peace and compassion."
Ocean Jasper carries a world of meaning, but if we had to choose just a few, our favorites would be: ease, flow, and grace—the way this stone gently guides us through life’s waves with a sense of calm and resilience.
What words come to mind when you connect with Ocean Jasper? We’d love to hear how this stone speaks to you!
Ocean Jasper is deeply connected to the Water element , making it a powerful ally for emotional healing, intuition, and flow . Just like the tides, this crystal teaches us to embrace change with grace , helping us release emotional blockages and ride the waves of life with ease. Its swirling, wave-like patterns mirror the gentle rhythms of the ocean, reminding us that healing is a journey, not a destination. Ocean Jasper’s energy soothes the heart, nurtures the spirit, and encourages deep emotional renewal , much like water cleanses and refreshes. Working with this stone invites fluidity, adaptability, and inner peace , making it an essential tool for anyone looking to balance their emotions, enhance their intuition, and move through life with a sense of trust and ease. 🌊✨
Ocean Jasper carries an energy that beautifully aligns with Pisces, Capricorn, and Cancer , each in a unique way:
♓Pisces (Feb 19 – Mar 20) – The Dreamer & Mystic
- Ocean Jasper resonates deeply with Pisces' fluid, intuitive nature , helping to balance emotions while enhancing joy, creativity, and spiritual insight.
♑ Capricorn (Dec 22 – Jan 19) – The Achiever & Grounded Leader
- Capricorn is known for discipline, ambition, and perseverance , but Ocean Jasper encourages them to release stress, go with the flow, and embrace joy.
♋Cancer (June 21 – July 22) – The Nurturer & Empath
- Cancer is deeply connected to home, emotions, and intuition , and Ocean Jasper nurtures their sensitive heart, bringing comfort, stability, and resilience.
Ocean Jasper is a silicon dioxide crystal, meaning it’s part of the quartz family . Its vibrant patterns and colors come from manganese, iron, and other mineral inclusions , which create the signature swirling or orb-like formations. These intricate patterns developed over millions of years , as mineral-rich solutions filled gas pockets within volcanic rock, slowly crystallizing over time.
How Long Did It Take to Form?
Ocean Jasper is estimated to have formed over 60 to 80 million years ago during the Late Cretaceous period. This was a time when dinosaurs still roamed the Earth, and volcanic activity played a huge role in shaping the land. As volcanic rock cooled, small gas bubbles became filled with silica-rich fluids, eventually solidifying into the stunning, patterned crystal we know today.
What is Silicon Dioxide?
Silicon dioxide ( SiO₂ ) is one of the most abundant minerals on Earth. It’s the same compound that makes up quartz, sand, and even glass ! You interact with it every day —whether walking on a beach (where sand is primarily composed of silica), using a glass window, or even working with modern technology (since silicon is a crucial component in computer chips).
A Connection to Everyday Life
Think of Ocean Jasper as nature’s ancient artwork , created through the same slow, patient forces that give us the sand beneath our feet and the glass in our windows . But unlike plain silica, this special formation carries millions of years of Earth’s history, energy, and transformation within it—making it not just a beautiful crystal, but a powerful tool for grounding, healing, and personal growth.
Further Readings
"With Ocean Jasper by my side, I flow through life’s waves with joy, patience, and an open heart, embracing each moment with gratitude and serenity"
Conclusion
Ocean Jasper claimed the #1 spot in our blog on the top stones of all time, and for good reason. We hope today’s post has inspired you to bring this incredible crystal into your own journey.
Working with Ocean Jasper feels like reconnecting with an old friend—warm, supportive, and always there when you need it. It offers a judgment-free space of kindness and encouragement, helping you navigate life’s twists and turns with grace.
We highly recommend this crystal for anyone on a spiritual path, especially those experiencing major life transitions—moving, marriage, divorce, loss, or the arrival of a child. These defining moments, our highest highs and lowest lows, feel softer, more manageable, and deeply supported with Ocean Jasper by your side.
Frequently Asked Questions
How do I cleanse my Ocean Jasper?
Ocean Jasper can be cleansed in multiple ways. Moonlight is one of the best methods—simply place it on a windowsill or outdoors under a full moon to recharge its energy. Smoke cleansing with sage, palo santo, or incense is another gentle yet powerful option. Brief exposure to sunlight can work, but prolonged direct sun may cause fading. You can also rinse it under running water for a quick energetic refresh, just be mindful not to soak it for too long.
Can I use water to cleanse my Golden Healer Quartz?
Yes! Ocean Jasper can be cleansed with water—simply rinse it under running water for about a minute. Just be sure to avoid prolonged submersion to preserve its natural beauty and energy.
Is Ocean Jasper ok for beginners?
Absolutely! Ocean Jasper is perfect for beginners—you’ll feel its soothing and uplifting energy right away. There’s no secret code or special ritual needed; simply hold it, carry it, or place it nearby, and let its gentle magic support you from day one!
Is Ocean Jasper an ethically sourced crystal?
While no crystal dealer can 100% guarantee a stone’s origins unless they own the mine, Ocean Jasper is generally ethically sourced and sourced from a vendor directly out of Madagacar. At Totems and Tarot, we prioritize working with reputable suppliers and avoid sourcing from regions involved in conflict, such as Afghan-mined Lapis. Integrity matters, and we do our best to ensure our crystals align with ethical practices.